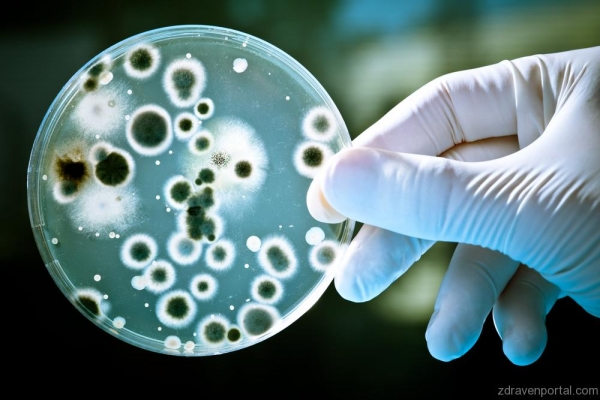

На крачка от научен пробив в борбата с опасните бактерии
Фармацевтичната компания Merck обявява, че е на крачка от научен пробив в борбата с опасните бактерии като ешерихия коли. Новият метод подлага микроорганизмите на глад, пише Tech Times. За да бъде разбран механизма на лекарството, е важно да се познават способностите на бактериите. Когато гладна бактерия не може да намери необходимите за оцеляването си витамини, тя е в състояние да ги синтезира.
Сегмент от РНК, наричан “рибозомен превключвател” управлява този процес.
Изследователите са открили молекула, която блокира превключвателя и лишава бактерията от способността да произвежда изключително важния за оцеляването й рибофлавин (витамин В2). Така на практика бактерията умира от глад. Изглежда, че убиващата бактерии молекула, която учените са нарекли “рибоцил” е достатъчно мощна, за да унищожи всички или повечето бактерии в гостоприемника.
Бактериите обаче са в състояние да засекат враждебната молекула, затова екипът е използвал отслабена форма на бактерия, за да скрие рибоцина. Все още не е ясно дали техниката ще успее да заблуди бактериите.
В търсене на нови антибиотици изследователите анализират хиляди химикали, като ефективните нови медикаменти почти винаги са протеини, но рибоцинът не е протеин. Той се прицелва към РНК, което отваря врата към нова област на проучвания, пише „Фокус”. По тази причина откритието е забележително. Учените посочват, че ще продължат да търсят начини да използват лекарството и да повишат ефективността му.
Zdravenportal.com
най-функционалният и посещаван сайт за здравеопазване в България
Най-големият Здравен портал в България, предоставящ информация за всички новини, новости и иновации в сферата на здравеопазването, медицината и подържането на здрав дух и здраво тяло. Свързващ Ви с най-добрите доктори, лечебни заведения и ветеринарни клиники. Предоставящ Ви възможността за онлайн запазване на часове. Zdravenportal.com съчетава в себе си качество и дизайн, преплетени с максимално удобство и улеснено меню за потребители търсещи, бърза и удобна връзка за здравни услуги, съвети и специалистите и заведенията, които ги предлагат.

Copyright ©2015 - 2026 www.zdravenportal.com by WebSolution Ltd.


